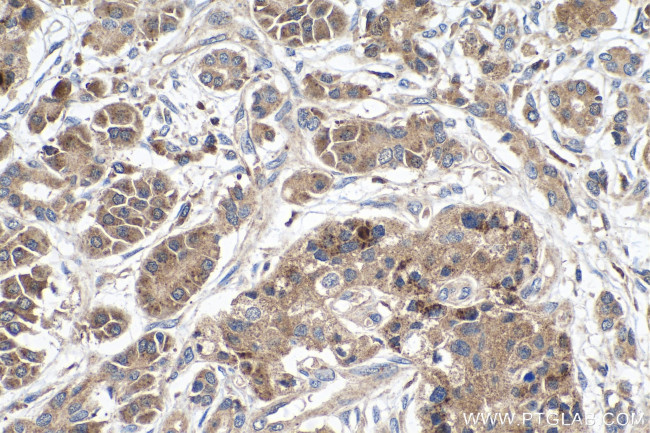
PCDHB10 Antibody in Immunohistochemistry (Paraffin) (IHC (P))

Search
Proteintech
PCDHB10 Polyclonal Antibody
{{$productOrderCtrl.translations['antibody.pdp.commerceCard.promotion.promotions']}}
{{$productOrderCtrl.translations['antibody.pdp.commerceCard.promotion.viewpromo']}}
{{$productOrderCtrl.translations['antibody.pdp.commerceCard.promotion.promocode']}}: {{promo.promoCode}} {{promo.promoTitle}} {{promo.promoDescription}}. {{$productOrderCtrl.translations['antibody.pdp.commerceCard.promotion.learnmore']}}
产品信息
14785-1-AP
种属反应
宿主/亚型
分类
类型
抗原
偶联物
形式
浓度
规格
纯化类型
保存液
内含物
保存条件
运输条件
产品详细信息
Immunogen sequence: FYILITEGAL DREIRAEYNI TITVTDLGTP RLKTEHNITV LVSDVNDNAP AFTQTSYTLF VRENNSPALH IGSVSATDRD SGTNAQVTYS LLPPQDPHLP LASLVSINAD NGHLFALRSL DYEALQAFEF RVGATDRGSP ALSREALVRV LVLDANDNSP FVLYPLQNGS APCTELVPRA AEPGYLVTKV VAVDGDSGQN AWLSYQLLKA TEPGLFGVWA HNGEVRTARL LSERDAAKHR LVVLVKDNGE PPRSATATLH LLLVDGFSQP YLPLPEAAPA QAQAEADLLT VYLVVAL
靶标信息
Potential calcium-dependent cell-adhesion protein. May be involved in the establishment and maintenance of specific neuronal connections in the brain.
仅用于科研。不用于诊断过程。未经明确授权不得转售。
篇参考文献 (0)
生物信息学
蛋白别名: PCDH-beta-10; Protocadherin beta-10; transmembrane glycoprotein; unnamed protein product
基因别名: PCDH-BETA10; PCDHB10; PCHB10; UNQ1906/PRO4352
UniProt ID: (Human) Q9UN67
Entrez Gene ID: (Human) 56126